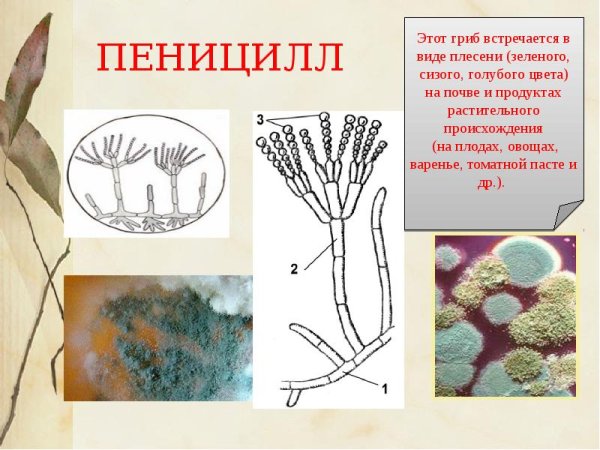
Строение плесени пеницилл

Пенициллин – это антибиотик, изначально полученный из плесени Penicillium. Он является одним из самых известных и широко используемых антибиотиков в медицине. Пенициллин применяется для борьбы с различными инфекционными заболеваниями, вызванными бактериями, такими как стафилококки и стрептококки. Его действие основано на уничтожении клеточной стенки бактерий, что приводит к их гибели. Пенициллин имеет низкую токсичность и хорошую переносимость, что делает его безопасным и эффективным лечебным средством. Рисунок пенициллина может быть использован для иллюстрации его молекулярной структуры или символизации его значимости в медицине.
Рисунок лекарства пенициллина
Пенициллин антибиотик рисунок
Конидии пеницилла
Пенициллин нарисовать
Фон для презентации пенициллин
Спорангиеносцы пеницилла
Пенициллин на белом фоне
Строение плесени пеницилл
Строение плесневого гриба пенициллина
Пенициллин гриб строение
Пенициллин и мукор
Спорангии на пенициллин
Первый антибиотик пенициллин
Строение плесневого гриба пеницилла
Плесневые грибы строение размножение
Прозрачный пеницилл
Плесневый гриб пеницилл
Пенициллин фон
Пенициллин конидиеносец
Конидии пеницилла
Гриб пеницилл строение
Пеницилл строение микробиология
Пеницилл обыкновенный
Пенициллин рисунок биология
Пенициллин вектор
Спорангии пеницилла
Пенициллин антибиотик рисунок
Конидии пеницилла
Конидиеносец пеницилла
Конидии пеницилла
Зеленая плесень пеницилл
Пенициллин и аспергилл
Плесневый гриб пеницилл
Плесневые грибы пенициллин
Пенициллин гриб строение
Пеницилл антибиотики рисунок
Penicillium chrysogenum конидиеносцы
Фенилбутазон структурная формула
Гриб пеницилл строение
Цефалоспорины химическая формула
Пенициллин гриб строение
Смотрите онлайн или можете скачать на телефон или компьютер в хорошем качестве совешенно бесплатно. Не забывайте оставить комментарий и посмотреть другие фотографии и изображения высокого качества, например голова котика рисунок и паяльник рисунок из раздела Рисунки

Grizly.club
Grizly.club